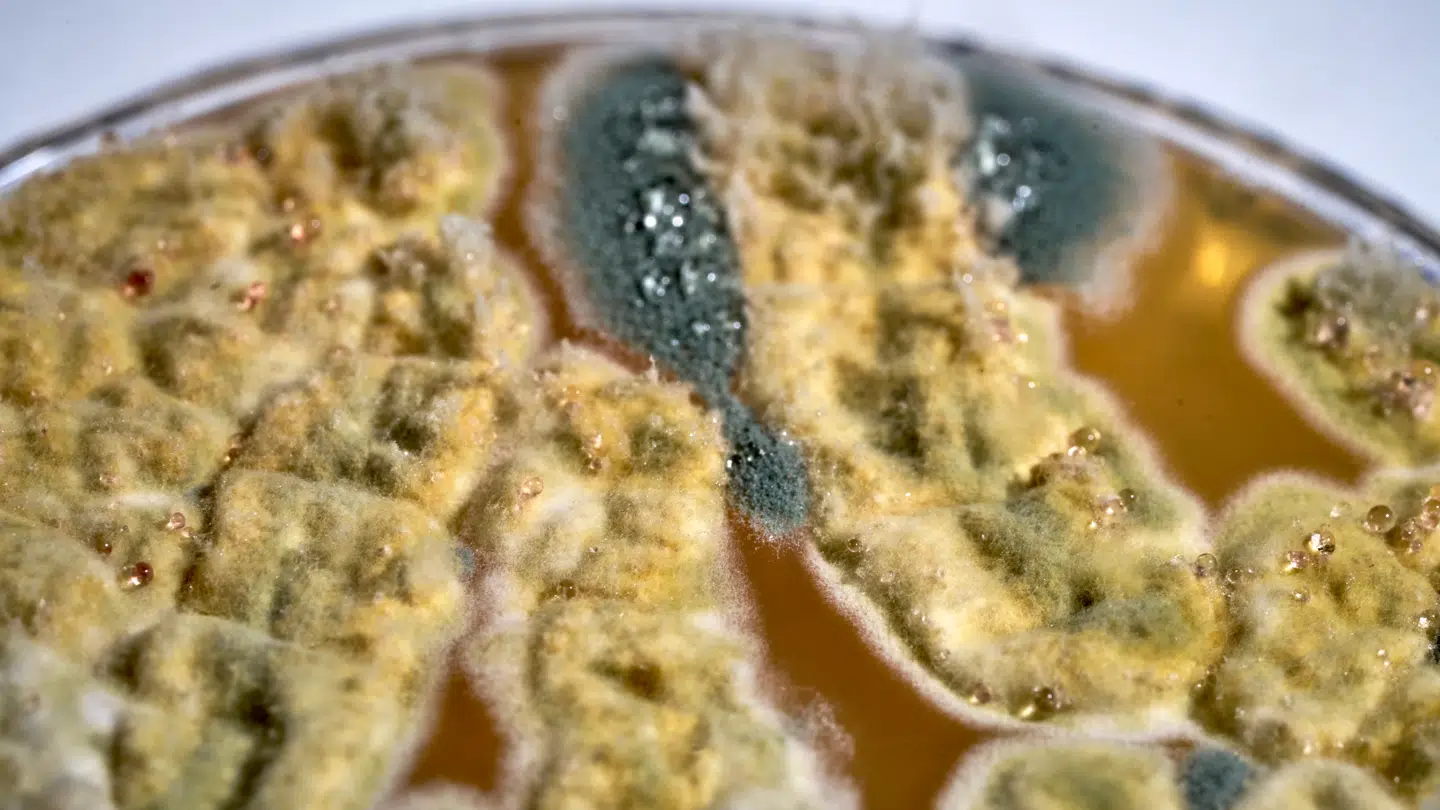
Her ses fugtens følgesvend, skimmel, som langsomt æder sig ind i danske hjem.

Skimmelsvamp kan smadre dit helbred: Hoste, åndenød, bronkitis, hududslæt, migræne, vægttab – ja selv hukommelsesproblemer og koncentrationsbesvær.
Nu giver to af landets førende eksperter de vigtigste råd: Sådan undgår du skimmelsvamp, sådan fjerner du det – og sådan kæmper du mod udlejer, når de nægter at lytte.
Fortsæt uden at betale en krone
Få adgang til artiklen, vores nyhedsbreve og mange flere login-fordele.
Se mereDel: